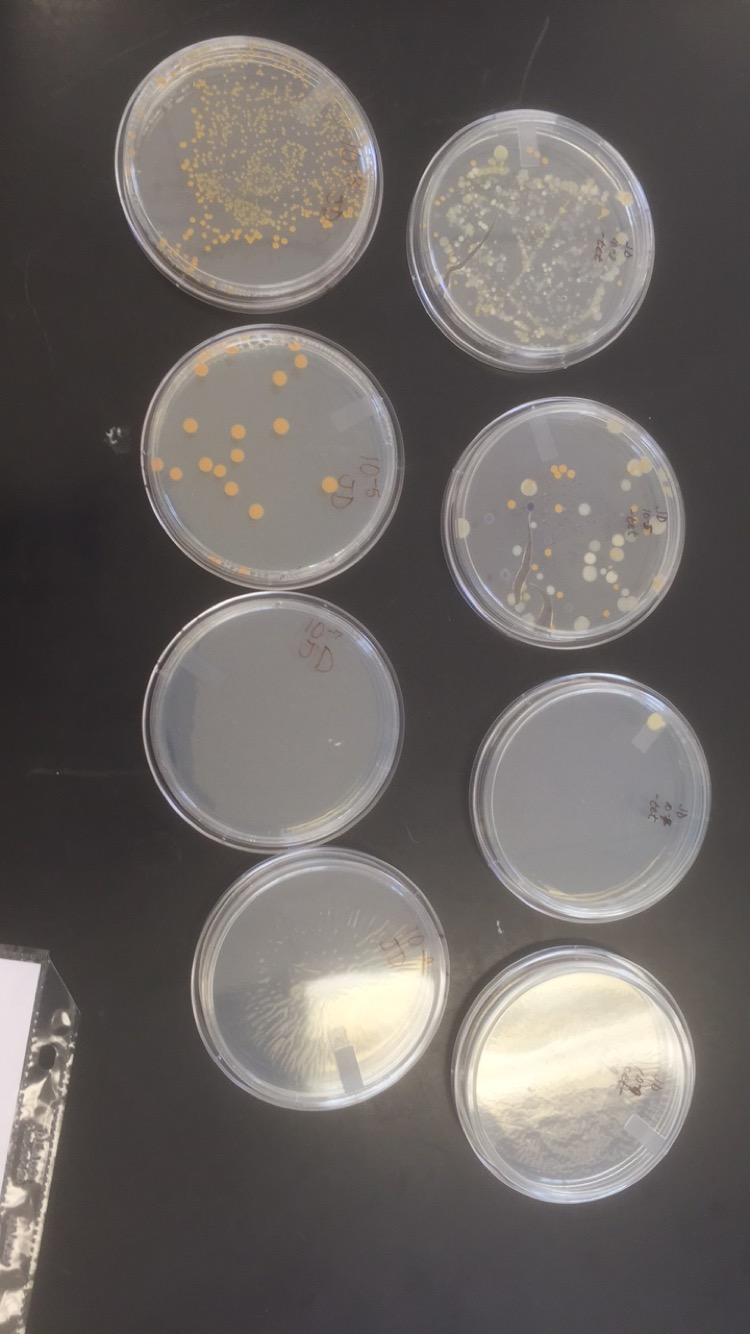

User:Emily Westin/Notebook/Biology 210 at AU
1/13/15 Purpose: Today we observed transect 4. The transect was flat, dry soil with various plants and a small duck pond. We recorded and observed both biotic and abiotic components of the transect. We also collected a sample of plants and water from the transect, as well as took photos of the area.
Materials and Methods: We observed and took pictures of Transect 4, located on the far east side of campus. We observed both biotic and abiotic components. We then collected samples of soil, water and plants in a Ziploc bag. We then added our samples to a jar of distilled water to prepare for our hay infusion culture for next week's lab.
Data and Observations: Biotic Components: 1. Grass 2. Microorganisms in the duck pond 3. Insects under rocks 4. Trees 5. Flower bushes
Abiotic components:
1. Rocks
2. Benches
3. Drain
4. Statue
5. Pond lights

Conclusions: It can be concluded from that lab that American University's campus has both biotic and abiotic components.
-E.W.
1/20/16 Dichotomous Key
Purpose: Today we observed a hay infusion culture and used a dichotomous key to identify the organisms within each slide. We did this to determine different organisms living in our transect, as well as observe components such as algal growth.
Materials and Methods: We made wet mounts of samples from our hay infusion culture from last week. We observed these wet mounts under the 10x, then under the 40x objectives. We recorded what we saw and used a dichotomous key to identify different organisms.
Data and Observations: The culture had a very unpleasant smell. It was mostly clear liquid with thick, slimy brown chunks settled near the top of the jar and on the bottom of the jar. There was brown/green algae present. Using the dichotomous key, we determined that Euglena was present in the culture. The organism that we observed looked like small, spiky twigs. It measured to be 12.5 micrometers. The organisms observed were non-motile, photosynthetic organisms.
Conclusions: We can conclude that if the culture was allowed to grow for another 2 months without interruption, it would most likely produce a foul odor and continue to support algae growth. We also concluded that there is a wide variety of species living in our transect.
1/29/16 Purpose: Today we observed the results from the agar plates set up from the previous week. The plates were set up from 10^-2, 10^-4, 10^-6, 10^-8, each getting 100 μL of the previous broth added to it. The agar plates used for these broths were labeled 10^-3, 10^-5, 10^-7, and 10^-9. The control agar plates were labeled 10^3, 10^5, 10^7, 10^9.
Materials and Methods: We took samples from the most populous plates and studied them under a microscope. We collected colonies from the plates using a metal loop that was heated in order to be sterilized. We picked up the colony with the sterilized loop, placed it on a wet mount slide and heated it to adhere it to the slide. We then used the gram stain procedure to stain the bacteria in order to make it easier to observe under the microscope. We then observed and recorded what we saw.
Data and Observations: The plates with only nutrient, 10^3 had 150+ colonies, 10^5 had 28 colonies, and 10^7 and 10^9 both had 0 colonies. For the nutrient and tet plates, 10^-3 had 150+ colonies, 10^-5 had 54 colonies, 10^-7 had 3 colonies, and 10^-9 had 0 colonies. The samples used for the gram stain slides were 10^3, 10^5, 10^-3, and 10^-5. The bacteria with the gram stain under the microscope looked rod-shaped. The gram was positive. 10^5 were enlarged rod-shaped, and were gram negative. 10^-3 were blue with black dots and cocci shaped, and were gram positive. 10^-5 were vibrio-shaped, and gram negative.
Conclusions: It can be concluded from this lab that plates with lower dilutions exhibited higher bacterial growth.
-E.W.
2/9/15 Plantae and Fungi Purpose: Today we collected leaf litter as well as 5 different types of plants from Transect 4.
Materials and Methods: We collected leaf litter from Transect 4 and set it up in a Berlese Funnel in order to collect invertebrates. We also collected 5 different types of plants and observed cross-sections of them under a microscope.We then observed each of the plants under the microscope and identified whether or not vascularization was present.
Data and Observations: Plant Descriptions: 1. Obtained from Transect 4. Oval-shaped, large, thick green leaves 2. Obtained from Transect 4. Smaller, thicker leaves than plant #1. Light green on the bottom, waxy, darker green on the top of the leaf. 3. Obtained from Transect 4. Long, thin leaves, rounded on top. 4. Obtained from Transect 4. Large, oval-shaped, red leaves with pointed tops. 5. Obtained from Transect 4. 3-Pointed tops, green, speckled large leaves.
Conclusions: From this lab, we can conclude that there is a wide variety of plant and foliage species located in Transect 4, and on American University's campus.
-E.W.
Invertebrates and Vertebrates 2/10/16 Purpose: In this lab, we examined the vertebrate and invertebrate species collected from the Berlese funnel. We made 3 petri dishes with the ethanol and organisms collected from transect 4, and examined them under a dissecting microscope.
Materials and Methods: We broke down the Berlese funnel and drained the ethanol and organisms into 3 separate petri dishes. We observed a large number of many different organisms, and used a pencil to move the organisms around under the microscope to view them from different angles.
Data and Observations: We found many different types of organisms, but the main 5 were classified as follows:
1. Phylum nematoda, 10 mm, 1 in sample, worm-like morphology 2. Siphonatetra, 2.5 mm, 3 in sample, jumping legs/flea-like 3. Phylum anthropoda, 5 mm, 3 in sample, worm-like with many legs 4. Phylum echinodermara, .75 mm, 4 in sample, beetle-like 5. Arachnid, 3 mm, 1 in sample, spider-like


Embryology and Development 2/16/16 Purpose: In this lab, we observed the embryology of frogs, starfish and chickens. We identified features such as blastulation, gastrulation, and cleavage. We then presented and prepared our Zebrafish experiments. Our experiment's purpose is to test the effects of nicotine on the development of zebrafish embryos.
Materials and Methods: We set up two trays labelled control and treated. 20 of the wells in the control tray were filled with 2mL of H2O and one embryo in each of the 20 wells. For the treatment wells, half were filled with 1mL of H2O and 1mL of treatment, and half were filled with 2mL of treatment and no H2O. Each of the 20 wells were given an embryo. The embryos were observed on the Friday of that week, and the Monday of the following week.
Data and Observations: Not much had changed when the embryos were checked on Monday. 2 of the wells in the control dish had live zebrafish that had hatched, but other than that, most of the embryos have yet to hatch.
2/17/16 Identifying Starfish, Chick, and Frog Embryos &Zebrafish Set-up Purpose: The first part of this lab was designed to train our eyes to recognize different stages of development in starfish, chick and frog embryos. Recognizing these stages of embryology was important in order to start the zebrafish experiments. The next portion of this lab was where students actually prepared for and set up their zebrafish experiments with their chosen variables.
Materials and Methods: In the first part of this lab, students looked at prepared slides of the stages of embryology for starfish, chick and frog embryos. We were instructed tio make observations and then fill out a table with results regarding the stages and characteristics of each stage, as seen in results section. In order to prepare and set up the zebrafish experiments, students prepared two different plates, one labelled control and one labelled treatment. The control dish received 2 microliters of H2O in each well, whereas the treatment plates received 2 microliters of the chosen variable, which, in our case, was nicotine. A zebrafish embryo was then added to each well with a transfer pipette.
Results:
 Frog embryonic stages:
Frog embryonic stages:




2/23/16 Checking in on Zebrafish
In today's lab we checked up on our zebrafish for a third time. We came in on Friday and Monday to document any growth or embryos that had died. The control plate had 13 live embryos, all of which were very active swimmers with no deformities. They also measured to be larger than the fish in the treatment wells. The embryos in the treatment wells only had 4 living embryos, and 5 dead, which were fixed in paraformaldehyde. 2of the embryos were very deformed, as shown in the image below. The embryos were not very active, and moved very slowly. They also measured to be smaller than the control embryos.


